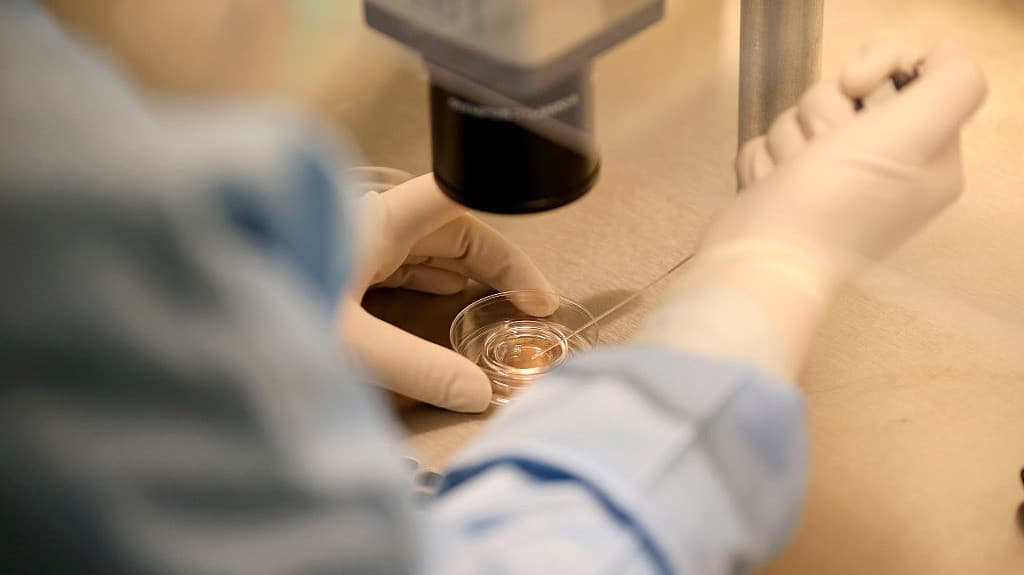

Investigadores de la Oregon Health & Science University han logrado por primera vez en la historia convertir células de la piel humana en óvulos y fertilizarlos con esperma en laboratorio, un avance que podría ayudar a las mujeres infértiles.
Óvulos humanos creados con células de la piel: el revolucionario hallazgo que podría acabar con la infertilidad
La técnica aún está a años de poder ser usada por futuros padres, advirtió el equipo de científicos. Sin embargo, expertos externos señalaron que esta investigación podría ser una respuesta a la infertilidad, que afecta a una de cada seis personas en todo el mundo.
La investigación publicada este martes en la revista Nature Communications detalla que el avance ofrece una vía potencial para la gametogénesis in vitro, que es el proceso de creación de gametos, con el fin de tratar la infertilidad en mujeres de edad materna avanzada o en aquellas incapaces de producir óvulos viables debido a tratamientos previos contra el cáncer u otras causas.
La técnica también podría usarse para que parejas del mismo sexo puedan tener un hijo con el cual estén relacionados genéticamente.
"Además de ofrecer esperanza a millones de personas con infertilidad por falta de óvulos o espermatozoides, este método permitiría la posibilidad de que las parejas del mismo sexo tuvieran un hijo genéticamente emparentado con ambos miembros de la pareja", afirmó la coautora del estudio Paula Amato, en un comunicado de la universidad.
El procedimiento aún está a años de poder ser usada por futuros padres, advirtió el equipo de científicos.
Sin embargo, expertos externos señalaron que esta investigación podría ser una respuesta a la infertilidad, que afecta a una de cada seis personas en todo el mundo.
¿Cómo crearon óvulos a partir de la piel?
Primero, los científicos extrajeron el núcleo de células de la piel y lo transfirieron a un óvulo donado al que previamente se le había retirado su núcleo, explica el comunicado.
Esta técnica, llamada transferencia nuclear de células somáticas, fue utilizada para clonar a la oveja Dolly en 1996.
Sin embargo, aún quedaba un problema por resolver: las células de la piel tienen 46 cromosomas, mientras que los óvulos tienen 23.
Para ello los científicos lograron eliminar los cromosomas adicionales mediante un proceso que llamaron "mitomeiosis", que imita la forma en que las células se dividen normalmente, dice el estudio.
Crearon 82 ovocitos, que luego fueron fertilizados con esperma mediante fecundación in vitro.
Después de seis días, menos del 9% de los embriones se desarrollaron hasta el punto en que hipotéticamente podrían ser transferidos al útero en un proceso estándar de in vitro.
"Ninguno de los embriones fue cultivado más allá de ese punto", dice el comunicado.
¿Por qué tardará tanto tiempo en que esta técnica sea utilizada?
De acuerdo con el estudio, los embriones mostraron diversas anomalías, por lo que el experimento fue suspendido.
Los investigadores señalaron varias limitaciones en su estudio, y que esperan al menos una década de investigación adicional antes de que el enfoque pueda ser considerado lo suficientemente seguro o eficaz como para avanzar a un ensayo clínico, incluso suponiendo que tal ensayo se permitiera en los Estados Unidos.
Pero estos resultados son lo suficientemente importantes como para despertar el entusiasmo de varios investigadores.
"Hemos conseguido algo que se creía imposible", afirma el autor principal, el doctor Shoukhrat Mitalipov, en el comunicado.
"La naturaleza nos dio dos métodos de división celular, y nosotros acabamos de desarrollar un tercero".
Según el estudio, los investigadores siguieron las directrices éticas vigentes en Estados Unidos sobre el uso de embriones.
Mira también: